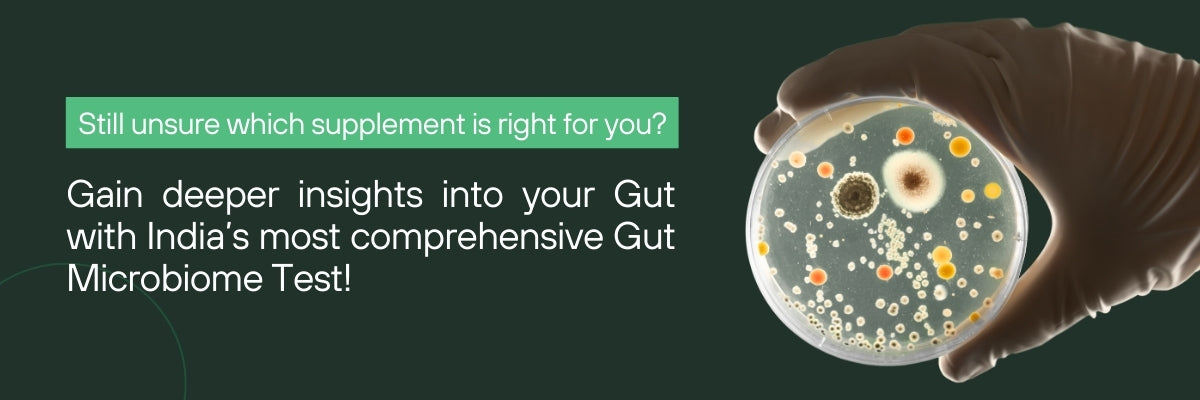

What is inside ?

Bifidobacterium lactis
Improves gut transit time. A faster transit time can prevent constipation. Improves stool consistency and frequency by increasing the production of short-chain fatty acids in the gut.

Bacillus coagulans
Helps regulate gut motility, which can improve bowel movements and reduce constipation. Reduces inflammation in the gut, which can improve gut function and alleviate constipation.

Bacillus Clausii
Improved gut transit time by increasing the production of enzymes that aid in digestion and absorption of food. Helps reduce inflammation in the gut and improve gut barrier function, which can alleviate constipation caused by gut inflammation or irritation.

Lactobacillus acidophilus
A type of probiotic that is commonly found in the human gut. It helps reduce bloating by improving the balance of gut bacteria and promoting the breakdown of indigestible carbohydrates.

Psyllium husk
A soluble fiber that is known to help regulate bowel movements and relieve constipation. It has been shown to reduce symptoms of irritable bowel syndrome (IBS) and inflammatory bowel disease (IBD).

Inulin
A prebiotic fiber that can be found in certain foods, such as chicory root, Jerusalem artichokes, and onions. Inulin has been shown to improve digestion and reduce bloating by feeding the good bacteria in the gut.

Polyethylene glycol
An osmotic laxative which helps in increasing the amount of water in the stool, making it easier to pass motion. P.E.G can be safely taken long-term, as it poses no risk of dependency or damage to the digestive system, fostering trust in its usage
Rooted in research
Frequently Asked Questions
-
How is One Swift Motion different from laxatives or churans?
One Swift Motion is made with a combination of fibres that promote easy and swift bowel movements every morning, including Psyllium husk, Inulin, P.E.G, Mg gluconate, and Elemental Zinc. This is paired with probiotic strains, making this formula more effective than herbal or single ingredient mixes by providing both instant relief as well as life-long benefits.
-
What results can I expect and by when?
By 20 days the microbial community will begin to restore balance and you'll notice a significant alleviation of symptoms. Within 2 months, your bowel movements will become more consistent, and by Day 120, you'll experience the utmost relief from constipation. There will be no discomfort or bloating, and your stools will be consistently well-formed. Beyond Day 120, The balance of the gut microbiome can be maintained through supplementation and a healthy lifestyle.
-
How can probiotics help with constipation?
One Swift Motion is made from a unique formulation consisting of 5 BN CFU & probiotic strains B. LACTIS BS-01, B. COAGULANS & B. CLAUSII which are most beneficial for constipation relief. When gut motility slows down, constipation can occur as gut bacteria control the rate of food movement through the digestive tract.
-
How does One Swift Motion work?
During constipation, the gut microbiome is imbalanced. Methane-producing bacteria slow intestinal transit time, causing dry and hard stool, leading to discomfort. When you take a probiotic, the balance of gut microbes starts to restore. Beneficial bacteria increase, aiding faster digestion and symptom relief. Within 2 months, improved balance and quicker digestion reduce discomfort. Regular bowel movements and significant constipation relief follow. This balance is upheld through supplementation and a healthy lifestyle.
-
Can Sova's Supplements be taken with other medication?
Our supplements are safe to consume with medication but it is always best to check with your health care provider. In the case of antibiotics, taking pre+probiotics together with antibiotics is safe and will not cause any adverse effects. However, antibiotics will drastically reduce the efficacy of probiotics because of their antibacterial properties. It is advisable to start taking the supplements one day after the antibiotics course is over.
-
Is it safe to take synbiotic supplements long-term?
All of the strains in Sova supplements are GRAS (generally recognised as safe) ingredients. There is no problem taking them long term.
-
Are there any side effects to taking synbiotic supplements?
Sova's supplements are safe, but a natural temporary process caused by the live bacteria taking effect may may cause temporary side effects such as bloating, gas, especially in the first 2 weeks.When you take pre+probiotic supplements containing live bacteria, they begin to populate your gut microbiome. This can cause some temporary side effects, such as bloating, gas, and mild digestive discomfort, especially in the first few weeks of use. This is because the new bacteria are interacting with the existing bacteria in your gut, and your gut microbiome is adapting to the new microbial environment.As the new bacteria begin to take effect, they may start to break down and ferment dietary fibers and other carbohydrates that are not typically digested by the body. This process can produce gas, which can lead to bloating and mild discomfort.While these side effects can be uncomfortable, they are generally considered to be a natural part of the process as your gut microbiome adapts to the new bacteria. In most cases, these side effects should subside within a few weeks as your gut microbiome adjusts.It is important to note that if you experience severe or prolonged side effects, or if you have a weakened immune system, SIBO, or other serious health conditions, you should consult with your healthcare provider before taking synbiotic supplements.







































